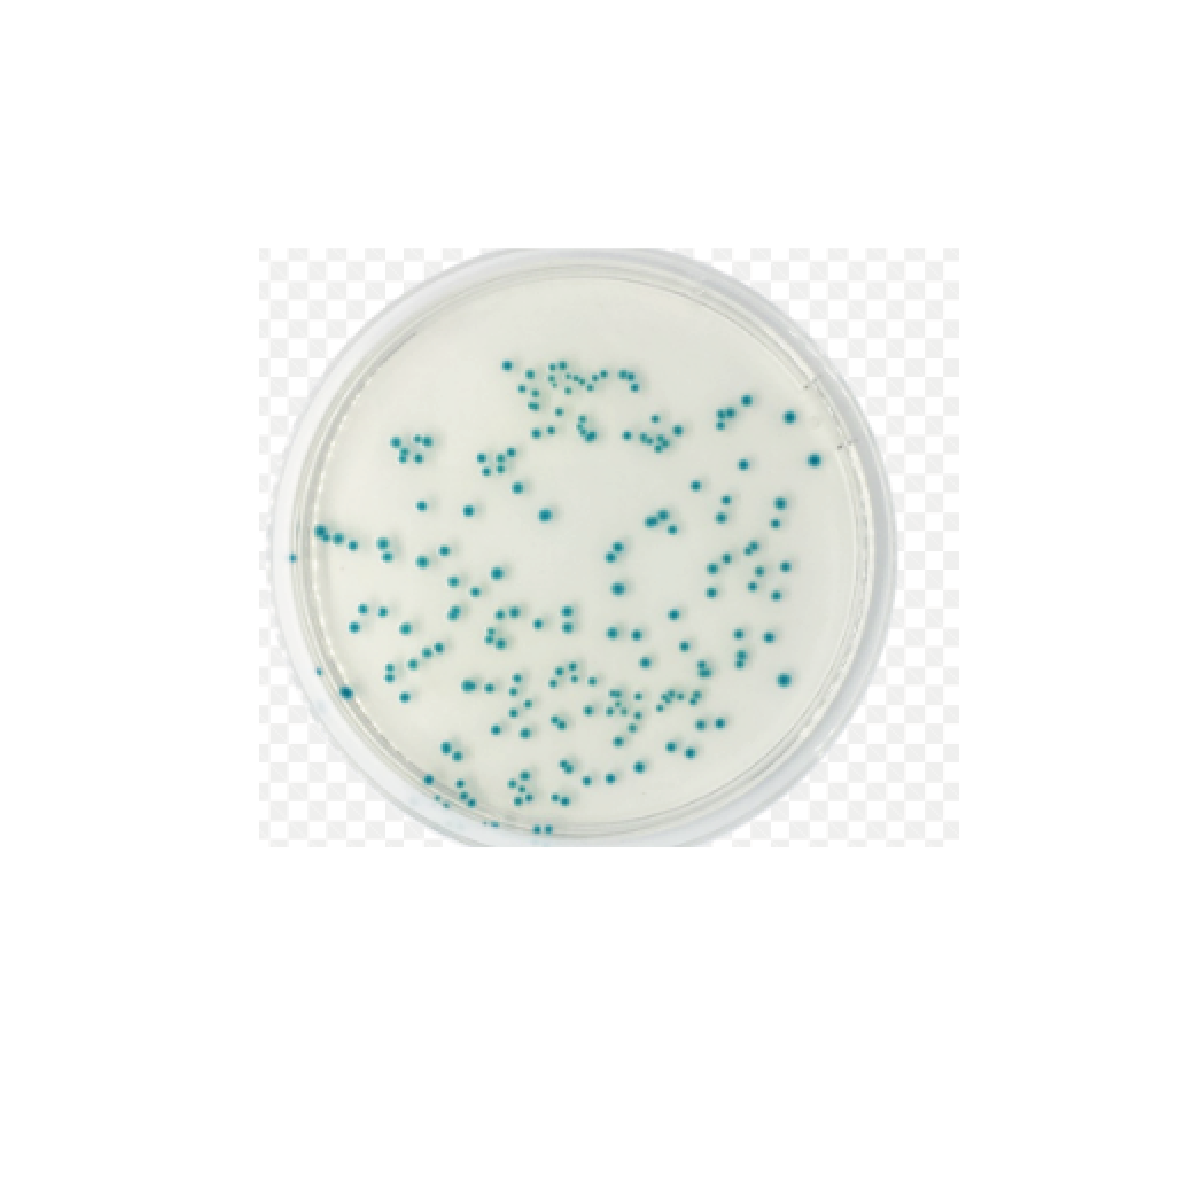
Tryptone Bile X-Glucuronide (TBX) Medium (Dehydrated) / Medio triptona bilis X-glucurónido (TBX) (deshidratado)

En Stock
Tryptone Bile X-Glucuronide (TBX) Medium (Dehydrated) / Medio triptona bilis X-glucurónido (TBX) (deshidratado)
[SKU: CM0945B]
Detecte y enumere Escherichia coli en muestras de alimentos y piensos con el medio Thermo Scientific™ Oxoid™ Typtone Bile X-glucurónido (TBX) (deshidratado). El medio cumple con los criterios de formulación y rendimiento establecidos en las normas ISO 16649 e ISO 11133:2014
S/ 0.00
Tryptone Bile X-Glucuronide (TBX) Medium (Dehydrated) / Medio triptona bilis X-glucurónido (TBX) (deshidratado)
Detecte y enumere Escherichia coli en muestras de alimentos y piensos con el medio Thermo Scientific™ Oxoid™ Typtone Bile X-glucurónido (TBX) (deshidratado). El medio cumple con los criterios de formulación y rendimiento establecidos en las normas ISO 16649 e ISO 11133:2014.
TBX Medium se basa en la velocidad, confiabilidad y recuperación de muestras congeladas y la detección de fermentadores deficientes de lactosa que ofrece el Tryptone Bile Agar original , con la adición de un agente cromogénico, X-glucurónido, que detecta la actividad de la glucuronidasa, una enzima que se muestra ser altamente específico para Escherichia coli